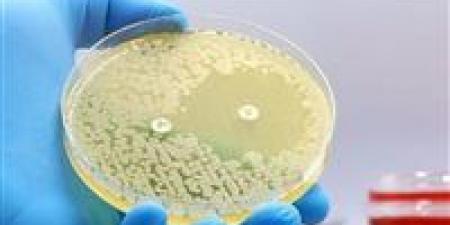
ثورة طبية .. الذكاء الاصطناعي يكتشف مضادات حيوية تهزم أخطر البكتيريا المقاومة

واقعة صادمة شهدتها إحدى مدارس الدقي، بعدما أحالت النيابة عاملًا بالمؤسسة التعليمية إلى محكمة الجنايات، لاتهامه بهتك عرض طفل.
البلاغ جاء من والدة الطفل، التي أكدت تعرض نجلها البالغ 9 سنوات للاعتداء داخل حمام المدرسة.
التحريات كشفت أن المتهم استدرج الطفل أكثر من مرة، مستغلًا وجوده داخل المدرسة، قبل ارتكاب جريمته.
الطفل روى تفاصيل الواقعة لوالدته، ما دفعها للتحرك القانوني الفوري، لتبدأ التحقيقات التي أثبتت صحة الاتهامات.
تم القبض على المتهم وحبسه احتياطيًا، قبل إحالته إلى الجنايات للفصل في القضية.
مد أجل الحكم في طعن "القائمة الوطنية".. جلسة حاسمة في مايو
لم تُسدل محكمة النقض الستار بعد على واحدة من أبرز الطعون الانتخابية، حيث قررت، اليوم السبت، مد أجل الحكم في الطعن رقم 67 لسنة 95، الخاص بإعلان فوز القائمة الوطنية من أجل مصر بدائرة غرب الدلتا، إلى جلسة 2 مايو المقبل.
وجاء القرار بعد جلسة شهدت غياب رئيس الهيئة الوطنية للانتخابات، رغم صدور حكم تمهيدي سابق باستجواب طرفي النزاع، ما أثار جدلًا قانونيًا داخل قاعة المحكمة.
المحامي نزيه الحكيم، مقيم الطعن، أكد أن غياب رئيس الهيئة يضعف موقف الخصم، مشيرًا إلى تمسكه بعدم قبول تمثيل هيئة قضايا الدولة عنه، لانتفاء الصفة القانونية.
وكانت المحكمة قد أصدرت حكمًا تمهيديًا باستجواب الأطراف، في محاولة لاستجلاء الحقيقة والفصل في نقاط الخلاف الجوهرية المرتبطة بصحة إعلان النتيجة.
يُذكر أن الطعن يمتد إلى شق دستوري، بعدما سبق للمحكمة الإدارية العليا إحالة بعض مواده إلى المحكمة الدستورية العليا، ما يزيد من تعقيد المشهد القانوني.
إصابة 4 في تصادم عنيف بين ميكروباص وتوك توك بقنا
تحول طريق دشنا في محافظة قنا إلى ساحة حادث مفاجئ، بعدما اصطدم ميكروباص بتوك توك بالقرب من كمين مصنع السكر، مخلفًا 4 مصابين.
تلقت الأجهزة الأمنية إخطارًا من غرفة العمليات يفيد بوقوع الحادث، لتتحرك على الفور قوات الشرطة وسيارات الإسعاف نحو موقع البلاغ.
وبالمعاينة الأولية، تبين أن التصادم وقع بشكل مباشر، ما أدى إلى إصابات متفاوتة بين الركاب، استدعت نقلهم إلى المستشفى لتلقي العلاج.
الأجهزة المعنية بدأت في رفع آثار الحادث وإعادة تسيير الحركة المرورية، مع اتخاذ الإجراءات القانونية اللازمة.
وتواصل جهات التحقيق فحص ملابسات الواقعة، فيما كُلفت المباحث بإعداد التحريات الكاملة حول أسباب التصادم.
تأجيل محاكمة 92 متهمًا في "خلية النزهة"
داخل قاعة محكمة بدر، قررت الدائرة الأولى إرهاب تأجيل محاكمة 92 متهمًا في القضية المعروفة إعلاميًا بـ"خلية النزهة" إلى جلسة 13 يونيو المقبل.
القضية تحمل في طياتها اتهامات ثقيلة، من بينها تولي قيادة جماعة إرهابية تهدف إلى الإخلال بالنظام العام وتعريض سلامة المجتمع للخطر.
كما نسبت التحقيقات إلى بعض المتهمين الانضمام إلى تلك الجماعة مع علمهم بأغراضها، إلى جانب اتهامات بتمويل الإرهاب.
أمر الإحالة تضمن تفاصيل دقيقة حول أدوار المتهمين، بين قيادات ومنضمين، في إطار مخطط يستهدف مؤسسات الدولة.
المحكمة قررت التأجيل لاستكمال الطلبات، وسط ترقب لجلسات قد تكشف المزيد من تفاصيل القضية.
بلاغ اختفاء يكشف جريمة قتل.. زوج ينهي حياة زوجته في العبور
بدأت القصة ببلاغ اختفاء، لكن النهاية كشفت جريمة قتل بشعة، بعدما تبين تورط زوج في إنهاء حياة زوجته بمدينة العبور.
الأجهزة الأمنية تلقت إخطارًا بتغيب ربة منزل، لتبدأ التحريات التي قادت إلى اكتشاف الجثة داخل نطاق المنطقة.
بالفحص، تبين أن الزوج وراء ارتكاب الواقعة، بدافع خلافات زوجية تصاعدت إلى جريمة مأساوية.
عقب تقنين الإجراءات، تم تحديد مكان المتهم وضبطه، ليواجه باعترافات كشفت تفاصيل ما جرى.
النيابة العامة قررت حبسه 4 أيام على ذمة التحقيق، مع التصريح بدفن الجثمان بعد الانتهاء من الصفة التشريحية.
تأجيل إعادة محاكمة متهمي "الجوكر" لجلسة يونيو
قررت الدائرة الأولى إرهاب تأجيل إعادة محاكمة 3 متهمين في القضية المعروفة إعلاميًا بـ"الجوكر" إلى جلسة 1 يونيو.
المتهمون يواجهون اتهامات بالتحريض على العنف ونشر أخبار كاذبة، في إطار أنشطة مرتبطة بجماعة إرهابية.
التحقيقات كشفت أن المتهمين سعوا لتكدير السلم العام عبر بث معلومات مغلوطة والتواصل مع قنوات معادية.
كما تضمن أمر الإحالة اتهامات باستخدام وسائل التواصل الاجتماعي لنشر أفكار تحريضية ضد الدولة.
المحكمة قررت التأجيل لمناقشة الباحث الاجتماعي، ضمن استكمال عناصر القضية.
تأجيل محاكمة خلية مدينة نصر.. واتهامات بقيادة تنظيم إرهابي
في قضية جديدة أمام محكمة الإرهاب، تقرر تأجيل محاكمة 15 متهمًا في خلية مدينة نصر إلى 13 يونيو.
أمر الإحالة أشار إلى أن بعض المتهمين تولوا قيادة جماعة تتبنى أفكار تنظيم القاعدة الإرهابي.
بينما انضم آخرون إلى التنظيم مع علمهم بأهدافه، ووجهت لهم أيضًا تهم تمويل الإرهاب.
القضية تمتد لسنوات، وتشمل وقائع منذ 2013 وحتى 2020، ما يعكس تشعب التحقيقات.
المحكمة قررت التأجيل للمرافعة، في انتظار عرض الدفاع والنيابة.
لقاء أمني مصري سوداني لتعزيز التعاون ومواجهة التحديات
في إطار العلاقات الوثيقة بين البلدين، استقبل وزير الداخلية نظيره السوداني بالقاهرة لبحث سبل التعاون الأمني.
اللقاء تناول تطوير آليات العمل المشترك وتبادل الخبرات، خاصة في ظل التحديات الأمنية الراهنة بالمنطقة.
الجانب السوداني أشاد بكفاءة الأجهزة الأمنية المصرية، معربًا عن رغبته في تعزيز التعاون التدريبي.
ومن جانبه، أكد الوزير المصري حرصه على دعم العلاقات وتبادل المعلومات لتحقيق الاستقرار.
الاجتماع اختُتم بالتأكيد على أهمية التنسيق المشترك لمواجهة التحديات الإقليمية.
تأجيل محاكمة “الهيكل الإداري للإخوان” إلى يونيو
قررت محكمة الإرهاب تأجيل محاكمة 63 متهمًا في قضية "الهيكل الإداري للإخوان" إلى 14 يونيو.
التحقيقات كشفت عن تولي قيادات داخل التنظيم إدارة هيكل تنظيمي يستهدف زعزعة الاستقرار.
كما وُجهت لباقي المتهمين تهم الانضمام للجماعة مع علمهم بأهدافها.
القضية تتضمن اتهامات بالإضرار بالوحدة الوطنية وتعطيل مؤسسات الدولة.
المحكمة أجلت القضية للمرافعة، تمهيدًا لاستكمال الإجراءات.
13 يونيو.. النطق بالحكم في قضية “خلية حلوان”
قررت محكمة الإرهاب حجز قضية “خلية حلوان” للحكم بجلسة 13 يونيو، بعد انتهاء المرافعات.
القضية تضم 11 متهمًا، بينهم قيادي متهم بتأسيس جماعة إرهابية.
التحقيقات أوضحت أن الجماعة سعت للإخلال بالنظام العام وتعطيل مؤسسات الدولة.
كما تورط بعض المتهمين في دعم التنظيم بالأدوات والمعدات.
الجلسة القادمة ستكون فاصلة في مصير المتهمين بعد رحلة محاكمة طويلة.
غموض حول وفاة سيدة داخل منزلها بالجيزة
في إحدى قرى الجيزة، عُثر على جثة سيدة داخل منزلها في ظروف غامضة، ما أثار تساؤلات حول ملابسات الوفاة.
الأجهزة الأمنية تلقت بلاغًا بالواقعة، وانتقلت قوة إلى مكان الحادث لإجراء المعاينة.
الفحص المبدئي أظهر أن السيدة كانت تقيم بمفردها بعد وفاة زوجها.
تم نقل الجثة إلى المشرحة، مع بدء التحقيقات لكشف وجود شبهة جنائية من عدمه.
وتكثف المباحث جهودها لكشف الحقيقة الكاملة وراء الواقعة.

0 تعليق